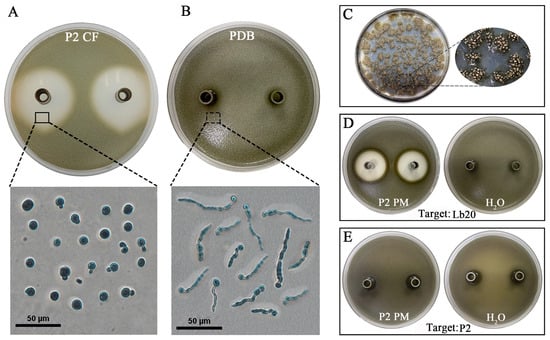
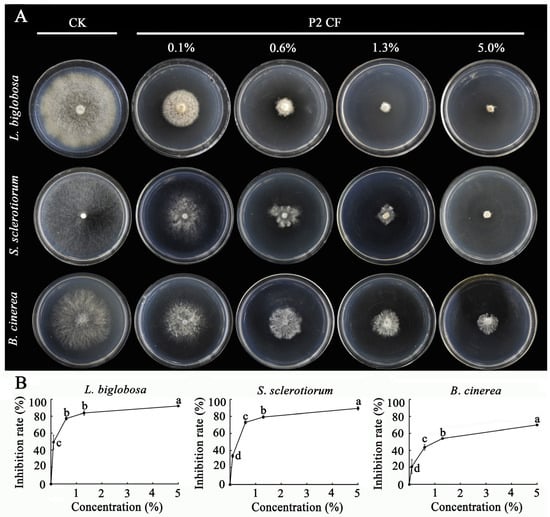

Abstract
Eight fungal strains (P1 to P8) were isolated from rapeseed stems (Brassica napus) infected with the blackleg pathogen Leptosphaeria biglobosa (Lb). They formed pycnidia with similar morphology to those of Lb, and thus were considered as Lb relatives (LbRs). The species-level identification of these strains was performed. Their virulence on rapeseed and efficacy in the suppression of Lb infection were determined, and the biocontrol potential and biocontrol mechanisms of strain P2 were investigated. The results showed that the LbRs belong to two teleomorphic genera in the family Didymellaceae, Didymella for P1 to P7 and Boeremia for P8. Pathogenicity tests on rapeseed cotyledons and stems indicated the LbRs were weakly virulent compared to L. biglobosa. Co-inoculation assays on rapeseed cotyledons demonstrated that P1 to P7 (especially P1 to P4) had a suppressive effect on Lb infection, whereas P8 had a marginal effect on infection by L. biglobosa. Moreover, D. macrostoma P2 displayed a more aggressive behavior than L. biglobosa in the endophytic colonization of healthy rapeseed cotyledons. Cultures of P2 in potato dextrose broth (PDB) and pycnidiospore mucilages exuded from P2 pycnidia showed antifungal activity to L. biglobosa. Further leaf assays revealed that antifungal metabolites (AM) of strain P2 from PDB cultures effectively suppressed infection by L. biglobosa, Botrytis cinerea (gray mold), and Sclerotinia sclerotiorum (white mold). An antifungal metabolite, namely penicillither, was purified and identified from PDB cultures and detected in pycnidiospore mucilages of strain P2. This study suggests that the LbRs are a repertoire for screening biocontrol agents (BCAs) against rapeseed diseases, and D. macrostoma P2 is a multi-functional BCA, a penicillither producer, and an endophyte.
1. Introduction
Rapeseed (Brassica napus) is a worldwide crop for edible vegetable oil, honey, livestock feedstuff, and green manure. In China, rapeseed has been widely cultivated both in the south as a winter crop and in the north as a spring crop, and has become the most important oil crop. The annual planting acreage has reached ~7 × 106 ha, and the annual seed yield has reached ~1.3 × 107 metric tons [1].
Like other crops, rapeseed encounters many fungal pathogens during growth and development, which cause diseases, resulting in substantial seed yield losses. Several rapeseed pathogens, such as Botrytis cinerea (gray mold), Leptosphaeria biglobosa (blackleg), L. maculans (blackleg), and Sclerotinia sclerotiorum (stem rot), are the top biotic threats worldwide to the rapeseed industry [2]. The control of blackleg (L. maculans) largely depends on the use of resistant varieties [3]. However, rapeseed cultivars usually lose ‘resistance’ to this disease after a certain period of cultivation due to the emergence of new races in the pathogen populations [4]. Furthermore, the Rlm gene in rape is not resistant to L. biglobosa, and no avirulent gene has been found in L. biglobosa [5]. On the other hand, the control of gray mold and Sclerotinia stem rot largely depends on the use of fungicides, as highly resistant rapeseed cultivars to B. cinerea and S. sclerotiorum are not yet available [6,7]. However, although fungicides are effective in most cases, the emergence of fungicide resistance renders fungicides ineffective for the control of these two diseases. Additionally, increasing public concerns over environmental pollution and fungicide residues in agricultural products warrant environmentally friendly alternative approaches to control these diseases. Therefore, it is necessary to develop new control measures (e.g., biological control) against rapeseed diseases.
Biological control using indigenous bacterial and fungal strains has been considered as a safe and sustainable approach for controlling plant diseases. Many biocontrol agents (BCAs) against rapeseed diseases have been reported. Mycoparasites such as Coniothrium minitans and Trichoderma spp. are effective BCAs against Sclerotinia stem rot [8,9]. Bird’s nest fungi such as Cyathus striatus, as well as bacterial antagonists such as Bacillus amyloliquefaciens, Pseudomonas chlororaphis, and Serratia plymuthica, have promising potential to control blackleg in rapeseed [10,11,12]. A few strains of Bacillus spp., C. minitans, and Trichoderma spp. have been successfully developed as commercial biofungicides [8,9]. They were mainly used for the control of diseases of high-value crops, such as vegetables, but rarely used for the control of rapeseed diseases, possibly due to low and inconsistent control efficacy, the narrow control spectrum, and the high cost. Therefore, it is necessary to explore novel BCAs to overcome these shortages.
Fungi in the genus Phoma and their related teleomorphs such as Didymella are widely distributed in diverse ecological niches associated with plants as plant endophytes, saprophytes, or pathogens [13,14,15]. More importantly, Phoma species are important sources of antimicrobial metabolites, which can be potentially exploited for the control of plant diseases [16]. For example, Phoma glomerata (telemorph: Didymella glomerata) was found to be an effective BCA against clubroot in cruciferous crops caused by Plasmodiophora brassicae through the production of cyclic tetramic acids [17,18,19]. Meanwhile, Sullivan et al. (2000) reported that the Phoma glomerata can also parasitize powdery mildew, which can produce a large number of pycnidia on cleistothecia, thus inhibiting the growth of powdery mildew [20]. Furthermore, the antifungal substances produced by the endophytic Phoma can inhibit the growth of Sclerotinia sclerotiorum, as well as Verticillium dahliae, the causal agent of verticillium wilt in malvaceous crops [21,22].
In our recent survey of the pathogens for blackleg in rapeseed in China, stems of rapeseed showing typical blackleg symptoms were collected from various rapeseed-producing areas in China [23]. A total of 6015 fungal strains were obtained; the majority of the strains (6007 strains, accounting for 99.9%) were L. biglobosa [23], and the remaining eight strains (P1 to P8) were considered to be L. biglobosa relatives (LbR) as they shared the same ecological niche (e.g., rapeseed stems) with L. biglobosa and formed black pycnidia and pycnidiospores that are morphologically similar to those formed by L. biglobosa. The peculiar association of the LbR strains with the blackleg disease promoted us to pose a few questions: Are the LbR strains as virulent as L. biglobosa/L. maculans against rapeseed? If they are not pathogens of rapeseed, do they have any biocontrol potential? What role can the LbR strains play in the rapeseed disease system with pathogens and plants? To address these questions, we conducted this study and reported herein results about the taxonomic identity of the eight LbR strains and some important biological characteristics, such as virulence on rapeseed and interaction with L. biglobosa and rapeseed. The results suggest that the LbR strains are an important source for screening BCAs against L. biglobosa and other rapeseed pathogens, and D. macrostoma P2 is a multifunctional BCA, a producer of antifungal metabolites, and an endophyte of rapeseed.
2. Materials and Methods
2.1. Fungal Strains and Cultural Media
A total of 25 fungal strains were used in this study, including 8 LbR strains (P1 to P8) and 15 Leptosphaeria strains (Table 1) as well as B. cinerea B05.10 and S. sclerotiorum Ss-1. The origins of the Leptosphaeria strains and the LbR strains are indicated in Table 1. B. cinerea B05.10 was provided by Dr. Zhonghua Ma of Zhejiang University (Hangzhou, China), and S. sclerotiorum Ss-1 was isolated from rapeseed. Five cultural media, including malt extract agar (MEA), oatmeal agar (OA), potato dextrose agar (PDA), potato dextrose broth (PDB), and water agar (WA), were used in this study. They were prepared using the procedures described by Fang (1998).

Table 1.
Fungal strains from rapeseed, collection place, and year, as well as GenBank accession numbers for ITS, LSU, tub2, and rpb2.
2.2. DNA Extraction, PCR, and Sequencing
The 8 LbR strains and the 15 Leptosphaeria strains were incubated on PDA overlaid with cellophane membrane; the cultures were incubated at 20 °C in the dark for 4 d. Mycelia of each strain were harvested using a sterilized aluminum spatula. Genomic DNA (gDNA) was extracted from the mycelia of each strain using the CTAB method and dissolved in Tris-EDTA (TE) buffer. DNA solutions (~50 ng/mL) were stored at −80 °C until use.
The gDNA was used as a template for the PCR amplification of the DNA sequences of ITS (internal transcribed spacer, ITS1-5.8S-ITS2), LSU (large subunit of 28S rRNA), tub2 (tublin), and rpb2 (the second subunit of RNA polymerase) using the primer pairs V9G/ITS4, LR0R/LR7, TUB2Fd/TUB4Rd, and fRPB2-5F/fRPB2-7cR, respectively (Table S1). The PCR mixture (25 μL) contained: 2.5 μL of 10× EasyTaq buffer (TransGen Biotechnol. Co., Ltd., Beijing, China), 50 μmol/L of dNTPs, 0.1 μmol/L of each primer, 0.75 U of Taq DNA polymerase (TaKaRa Biotechnol. Co., Ltd., Dalian, China), 50 ng of DNA template, and ddH2O. The PCR was performed in a S1000TM Thermal Cycler (Bio-Rad Laboratories, Hercules, CA, USA) with the thermal programs listed in Table S2. The PCR products were cloned and sequenced using routine procedures [24]. The DNA sequences were deposited in the GenBank public database (http://www.ncbi.nlm.nih.gov (accessed on 28 November 2023)), and their GenBank accession numbers are listed in Table 1.
2.3. Phylogenetic Analysis
Multiple DNA sequences of ITS, LSU, tub2, and rpb2 for 36 fungal taxa (Table 1 and Table S3) were aligned using Clustal W in MEGA X [25] with default settings. The dataset was used to construct phylogenetic trees using the procedures described by Guo et al. [26]. Bayesian inference (BI) was used to construct phylogenies using MrBayes v. 3.1.2 [27]. The best-fit model for nucleotide substitution in each partition was determined as GTR + I + G using MrModeltest v. 2.3 [28]. Two analyses of four Markov Chain Monte Carlo (MCMC) chains were conducted from random trees with 6 × 106 generations. The analyses were sampled every 1000 generations, which were stopped once the average standard deviation of split frequencies was below 0.01. The first 25% of the trees were discarded as the burn-in phase of each analysis, and the remaining trees were summarized to calculate the posterior probabilities (PPs) of each clade being monophyletic.
Additionally, maximum parsimony analyses (MPs) were performed on the multi-locus alignment using PAUP (Phylogenetic Analysis Using Parsimony) v. 4.0b10 [29]. Phylogenetic trees were generated using the heuristic search option with Tree Bisection Reconnection (TBR) branch swapping and 1000 random sequence additions. Maximum trees were set up to 5000, branches of zero length collapsed, and all multiple parsimonious trees were saved. Clade stability was assessed using a bootstrap analysis with 1000 replicates. Then, tree length (TL), consistency index (CI), retention index (RI), rescaled consistency index (RC), and homoplasy index (HI) were calculated. Furthermore, raxmlGUI-2.0.0 [30] was used for maximum likelihood (ML) analysis. The analysis was performed with a GTR site substitution model. The branch support was evaluated with a bootstrapping (BS) method of 1000 replicates [31]. The phylogenetic tree was visualized in FigTree v. 1.4.2 [32] and deposited in TreeBASE (https://treebase.org/treebase-web/home.html (accessed on 28 November 2023)) with the accession number Study 27919.
In order to further define subspecies status of the 15 Leptosphaeria strains, another dataset containing DNA sequences of ITS and LSU was established to accommodate 38 fungal taxa (Table 1 and Table S3). It was used to construct another phylogenetic tree with the same procedures described above. The tree was also deposited in TreeBASE with the accession number Study 27916.
2.4. Morphological Characterization
The eight LbR strains (P1 to P8) and L. biglobosa Lb20 were cultured on MEA, OA, and PDA in Petri dishes (90 mm in diameter; 20 mL of medium in each dish), with five dishes (replicates) for each strain. The cultures were incubated at 20 °C in the dark, the diameter of each fungal colony was measured after incubation for 4 and 6 d, and the data were used to calculate the radial mycelial growth rate, expressed as mm per day. After incubation for 7 to 14 d, the morphological features of the colonies were observed based on description by Chen et al. [33]. The size of randomly selected 20 pycnidia and 50 pycnidiospores for each strain was measured under a compound light microscope (Model Nikon 80i, Tokyo, Japan). To observe the morphology of pycnidia, a mycelial agar plug with mature pycnidia was carefully removed from a 14-day-old PDA culture; it was then immersed in formalin–acetic acid–alcohol (FAA) fixative solution (formalin/glacial acetic acid/50% ethanol, 5/5/9, v/v/v). The specimens were dehydrated with serial ethanol solutions (70% to 100%, v/v), embedded in paraffin wax, and sectioned. The resulting thin slices were mounted on glass slides, followed by de-waxing, rehydration, hematoxylin–eosin staining, and observation under the compound light microscope.
2.5. Virulence Determination
The virulence of the eight LbR strains was determined on cotyledons and basal stems of rapeseed (B. napus cultivar Zhongshuang No.9) in comparison with L. biglobosa Lb20. The nine strains were incubated on PDA at 20 °C for 15 d; pycnidisopores were harvested by washing the PDA cultures with sterile distilled water for the preparation of pycnidiospore suspensions (1 × 107 spores/mL), which were used as inoculum in the following two trials.
In the cotyledon inoculation trial, rapeseed seeds were pre-germinated at 20 °C on moisturized filter papers for 3 d. The germinated seeds were then sown in plant potting mix (N:P:K = 1:1:1, pH 6) in plastic pots (10 × 10 cm, diameter × height), and the pots were maintained for 14 d in a growth room (20 °C, 16 h light/8 h dark) and watered as needed. The cotyledons were wounded using a needle, with two wounds (one on each side of the main vein) per cotyledon. An aliquot (10 μL) of the pycnidiospore suspension of each strain was applied on the wounds and surrounding area, with 16 wounds on eight cotyledons (4 seedlings) for each strain. For the control treatment, sterile water (10 μL) was applied to 16 wounds on eight cotyledons. The treated seedlings were transferred to a plastic container in a growth room (20 °C, 16 h light/8 h dark) to maintain high humidity (~100% R.H.). The lesion diameter around each wound was measured at 7 d post-inoculation (dpi).
In the stem inoculation trial, the pycnidiospore suspensions of each strain and water alone (control) were inoculated into pre-wounded basal stems of 60-day-old rapeseed plants using a micropipette, with 10 μL on each wound and six stems for each strain and control. Then, the basal stems were wrapped at the wound areas with plastic film, and the treated plants were maintained outside (15 °C to 25 °C) for 21 d; the lesion length and width on the stem epidermis and inside the stem pith were measured around each wound.
2.6. Co-Inoculation Assays
Assays were carried out to determine the effects of the LbR strains on infection by L. biglobosa. The pycnidiospore suspensions (1 × 107 spores/mL) of the LbR strains and L. biglobosa Lb20 were prepared as mentioned above. There were six treatments for each combination of an LbR strain and Lb20, namely six different ratios of pycnidiospore suspensions of an LbR strain and Lb20 at 2:8, 3:7, 5:5, 7:3, 8:2, and 10:0 (LbR:Lb20, v/v). Meanwhile, six control treatments, namely six mixtures of sterile water and pycnidiospore suspension of Lb20 with the ratios at 2:8, 3:7, 5:5, 7:3, 8:2, and 10:0 (water:Lb20, v/v), were separately set up. The mixture (10 μL) for each treatment was inoculated on 12 wounded cotyledons on six rapeseed seedlings (14 days old). The treated seedlings were maintained in the growth room (20 °C, 100% R.H.) for 7 d, and the lesion diameter around each wound was measured. The assay was repeated three times.
An additional experiment was carried out to assess the association of endophytic growth of P2 with its suppressive effect on infection by L. biglobosa Lb20. The mixture of pycnidiospore suspensions (1 × 107 spores/mL) of P2 and Lb20 (1:1, v/v), as well as the mixture of water and the pycnidiospore suspension of Lb20 (1:1, v/v), was separately set up and inoculated at wounded cotyledons, with 10 μL on each wound and 80 wounds on 20 seedlings for each treatment. The treated seedlings were incubated in the growth chamber (20 °C) for 7 d, and the lesion diameter around each wound was measured. After measuring the lesion size, the endophytic growth of P2 and Lb20 in the cotyledons in the treatment of P2 and Lb20 in all of the three trials and in the cotyledons in the treatment of water and Lb20 in the third trial was zoned around the center of each wound towards the margin: 10 mm in width for each zone and three zones (Z1, Z2, Z3) on each cotyledon. The tissue of each zone was cut into small pieces (3 × 3 mm in size) using a sterilized razor blade; the resulting cotyledon pieces (CP) were surface-disinfected with 5% NaClO and placed on acidified PDA, with 8 CPs in each dish and 40 CPs in total for each zone. The dishes were placed in an incubator (20 °C) for 5 d; fungal colonies formed around the CPs were identified based on the colony morphology of P2 and Lb20. The isolation frequency of each fungus was calculated based on the number of CPs with that fungus and the total number of CPs used in isolation. The experiment was repeated three times as three trials in this assay.
2.7. Suppression of Fungal Infection by Cultural Filtrates of LbR Strains
The LbR strains were shake-cultured (20 °C, 150 rpm) in PDB for 15 d. The cultural filtrate (CF) of each strain was collected by filtering the cultures through four-layer cheesecloth, followed by centrifuging at 6000 rpm for 5 min to remove hyphal fragments. The resulting supernatant was used to treat rapeseed leaves of 30-day-old plants. Three leaves on a plant were selected and wounded with a needle (two wounds on each leaf (one on each side of the main vein)). Filter paper disks (5 mm in diameter) were placed on the wounds to help hold the CF as well as the pycnidiospore suspension of L. biglobosa Lb20. The CF of each strain or fresh PDB (control) was applied to the filter paper disks, with 20 μL of CF on each disk and 15 leaves for each strain and control. Three hours later, aliquots (10 μL) of the pycnidiospore suspension (1 × 107 spores/mL) of L. biglobosa Lb20 were pipetted onto the filter paper disks that were pre-treated with the CF or water. The inoculated seedlings were maintained under humid conditions (100% R.H.) in the growth room (20 °C) for 7 d. The leaf lesion diameter around each filter paper disk was measured. The bioassay was repeated three times.
The P2 CF was further tested for the suppression of infection by S. sclerotiorum Ss-1 and B. cinerea B05.10 on rapeseed leaves. There were four treatments: P2 CF+Ss-1, Ss-1 alone (Control 1), P2 CF+B05.10, and B05.10 alone (Control 2). In the treatments of P2 CF+Ss-1 and P2 CF+B05.10, the P2 CF was sprayed evenly on leaves of 30-day-old rapeseed plants, with ~0.5 mL of P2 CF or PDB on each leaf. In the treatments of Ss-1 alone and B05.10 alone (Control 1 and Control 2), fresh PDB (~0.5 mL per leaf) was sprayed evenly on leaves of rapeseed. There were 12 leaves on four plants for each treatment. Three hours later, the leaves were inoculated with mycelial agar plugs (5 mm in diameter) of S. sclerotiorum Ss-1 or B. cinerea B05.10, with two mycelial agar plugs (one on each side of the main vein) per leaf. The inoculated plants were maintained in a moist chamber (20 °C, 16 h light/8 h dark) for 3 d, and the leaf lesion diameter around each mycelial agar plug was measured. The bioassay was repeated two times.
2.8. Determination of the Antifungal Activity of P2 Cultural Filtrate
Two methods, agar diffusion and agar amendment, were used to determine the antifungal activity of P2 CF from 15-day-old PDB cultures. The agar diffusion method was used to determine the suppression of pycnidiospore germination of L. biglobosa Lb20. The pycnidiospore suspension (1 × 108 spores/mL) of L. biglobosa was incorporated into PDA at the ratio of 1:9 (v/v), and the spore-containing medium was distributed in Petri dishes (~20 mL in a 9 cm diameter dish). Sterilized Oxford cups (10 × 6 mm, height × inner diameter) were placed on the spore-containing PDA in the dishes, with two cups in each dish and three dishes as six replicates (cups) for each treatment. The P2 CF or fresh PDB (control) was pipetted into the Oxford cups (200 µL per cup). The dishes were maintained in an incubator (20 °C) for 4 d, and the diameter of the inhibition zone around each cup was measured.
The agar amendment method was used to determine the suppression of mycelial growth of L. biglobosa, S. sclerotiorum, and B. cinerea. The P2 CF from the 15-day-old PDB cultures was incorporated into PDA at concentrations of 0% (Control), 0.1%, 0.6%, 1.3%, and 5.0% (v/v), and PDA alone was treated as control. The mycelial agar plugs of each target fungus were inoculated on PDA supplemented with P2 CF or on PDA alone (control), with one mycelial agar plug per dish and three dishes (replicates) for each treatment. The cultures were incubated at 20 °C, and fungal colony diameters were measured at 3 d for B. cinerea and S. sclerotiorum and at 15 d for L. biglobosa, and the diameter of the fungal colony in each dish was measured. The percentage of colony size reduction (CSR) to indicate mycelial growth inhibition rate by P2 CF was calculated using the following formula:
where ADCK represents the average colony diameter of a target fungus in the control treatment, and DCF represents the colony diameter of that fungus in the treatment of P2 CF at a given concentration.
CSR (%) = 100% × (ADCK − DCF)/ADCK
2.9. Determination of the Antifungal Activity of P2 Pycnidiospore Suspensions
Strain P2 was inoculated on PDA at 20 °C in the dark for 15 d. Sterile distilled water was added to the cultures, and pycnidiospores in mucilages exuding from pycnidia were washed off by gently scraping the cultures using a sterilized glass rod. The spore mixture was filtered through four-layer cheesecloth to remove hyphal fragments and obtain pycnidiospore suspension. The concentration of pycnidiospores was measured using a hemocytometer and adjusted to 1 × 108 spores/mL with sterile distilled water. The pycnidiospore suspension was centrifuged at 6000 rpm for 10 min to precipitate the pycnidiospores. The resulting supernatant contained substances from pycnidiospore mucilages. It was designated here as P2 PS (e.g., pycnidiospore-associated substances). The antifungal activity of P2 PS towards L. biglobosa Lb20 and D. macrostoma P2 itself was then tested using the agar diffusion method mentioned above with water as the control.
2.10. The Extraction and Purification of Antifungal Metabolites
The antifungal metabolites in P2 CF were extracted using the chloroform isolation method outlined in Figure S1. A brown powder (~8 g) of the chloroform extract (P2 CE) was obtained. It was dissolved in 10 mL of methanol, and the resulting solution was subjected to silica gel chromatography using a mixture of chloroform and methanol as gradient eluents. A total of 20 serial fractions (200 mL for each) were obtained and vacuum-lyophilized. Then, the dried fractions were separately dissolved in methanol, and the antifungal activity of the resulting solutions was tested using the agar diffusion method mentioned above with L. biglobosa as a bio-indicator.
2.11. Identification of Penicillither
The fraction Fr.4 (Figure S1) was further purified by semi-preparative HPLC, and a pure sub-fraction Fr.4.4 was obtained (Figure S1). Electrospray ionization mass spectrometry (ESI-MS), ultraviolet absorption, and nuclear magnetic resonance spectroscopy (NMR) were used to determine the chemical formula and structure of Fr.4.4. The ESI-MS analysis was performed on Waters ACQUITY UPLC coupled with ACQUITY UPLC® BEH C18 column (1.7 μm, 2.1 mm × 50 mm). Fr.4.4 was dissolved in methanol, and the resulting solution (1 μg/mL, 1 μL) was injected into the HPLC instrument. The column was eluted with mixtures of flow phases A (100% acetonitrile) and B (99.9% water + 0.1% formic acid, v/v). The operating parameters were set as foolows: capillary voltage at 2.0 kV, cone voltage at 30 kV, Z-spray source temperature at 120 °C, desolvation temperature at 450 °C, gas flow at 800 L/h, mass range from 50 to 1200 m/z. The mass spectrum was collected in negative and positive modes and used to determine the element composition of Fr.4.4 using Waters mass spectrometry software Masslynx v4.1. The resulting information about molecular mass and formula was searched in CAS SciFinder® (https://scifinder.cas.org (accessed on 28 November 2023)) to confirm chemical identity.
To determine the ultraviolet absorption spectrum, the methanol solution of Fr.4.4 (100 μg/mL) was pipetted into a colorimetric tube (500 μL), which was placed in a UV2600 UV-VIS photometer (Shimadzu, Kyoto, Japan). The ultraviolet absorption spectrum of the solution at 200 to 700 nm was then determined.
To determine NMR spectra, Fr.4.4 was dissolved in 500 μL of DMSO-d6 (Sigma-Aldrich®, St. Louis, MO, USA), and the resulting solution (6 μg/μL) was pipetted into a nuclear magnetic tube (5.0 × 177.8 mm, Sigma-Aldrich®), which was then placed in a full digital superconducting NMR spectrometer (AVANCE III 600 MHz, Brucker, Karlsruhe, Germany) to determine 1H-NMR and 13C-NMR spectra. Tetramethylsilane (0.03%, w/v) was used as the internal standard in NMR.
2.12. The Quantification of Penicillither
Solutions of purified penicillither at five concentrations (6.2, 12.5, 25.0, 50.0, 100.0 μg/mL) were prepared. They were separately injected (1 μL for each solution) in Shimadzu LC-20AT HPLC with a Thermo Scientific UMISil C18 (Thermo Scientific, Waltham, MA, USA) column (5 μm, 250 × 4.6 mm) and Shimadzu SPD-20A UV detector. The compounds were eluted using the same elution phases and programs mentioned above to collect the absorbance peaks; the data, together with concentrations of the two compounds, were used to establish standard curves. Then, P2 CF, P2 CE, and P2 PS (1.0 × 108 spores/mL) were separately injected into HPLC to determine the absorbance peaks of penicillither, and the data were used to calculate the content or concentration of these two compounds with the standard curves as a reference.
2.13. Data Analysis
Data for different treatments in each experiment or bioassay were analyzed using the procedure of Analysis of Variance (ANOVA) in the SAS software (SAS Institute, Cary, NC, USA, V. 8.0, 1999). The percentage data on colony size reduction (CSR) and lesion size reduction (LSR) by the cultural filtrates (CFs) of the LbR strains were transformed by multiplying the original data by 100 before ANOVA. After ANOVA, they were back-transformed to percentage values. The treatment means of each parameter in different treatments were separated using the least significant difference (LSD) test (α = 0.05). Data on leaf lesion diameters caused by B. cinerea (or S. sclerotorum) in the treatments of P2 CF and control were analyzed using the procedure Univariate in SAS. The average leaf lesion diameters between P2 CF and control were compared using Student’s t test at α = 0.05 or 0.01.
3. Results
3.1. The Species Identity of the LbRs
Two phylogenetic trees were constructed based on the combined sequences of ITS, LSU, tub2, and rpb2 for 36 fungal taxa as well as the combined sequences of ITS and LSU for 38 fungal taxa. Both trees appeared very similar in topology. They consisted of two clades corresponding to two families, Didymellaceae and Leptosphaeriaceae (Figure 1 and Figure S2). The 8 LbR strains as well as the 10 reference strains of Boeremia exigua, Didymella spp., and Phoma herbarum were located in the clade of Didymellaceae. Strains P1 and P3 are closely related to D. bellidis, and they formed two unique branches distinct from that for D. bellidis, suggesting that they might be two novel species of Didymella; strains P2 and P4 are closely related to D. macrostoma (anamorph: Phoma macrostoma) and D. glomerata (anamorph: Phoma glomerata), respectively; strains P5, P6, and P7 are closely related to D. macropodii (anamorph: Phoma nigrificans); and strain P8 is closely related to Boeremia exigua (anamorph: Phoma exigua). The phylogenetic analysis also showed that 15 strains of Leptosphaeria were located in the clade of Leptosphaeriaceae (Figure 1 and Figure S2). They are closely related to the sub-clade of L. biglobosa ‘brassicae’.

Figure 1.
A Bayesian inference phylogenetic tree of 36 fungal taxa. The tree was constructed using concatenated sequences of ITS, LSU, rpb2, and tub2. Bayesian posterior probability (PP ≥ 0.90), RAxML bootstrap support values (ML ≥ 50%), and MP bootstrap support values (MP ≥ 50%) are shown at the nodes (PP/ML/MP). Scale bar indicates 0.3% sequence divergence.
3.2. Morphological Characteristics
The eight LbR strains and L. biglobosa Lb20 differed in growth rates on MEA, OA, and PDA, and in the morphology of colonies, pycnidia, and pycnidiospores (Table 2). Two LbR strains (P5, P8) and L. biglobosa Lb20 grew slowly on at least one of these media, with the average growth rates ranging from 0.7 to 1.8 mm/d on MEA, from 2.0 to 2.4 mm/d on OA, and from 1.5 to 2.3 mm/d on PDA. The remaining six LbR strains (P1, P2, P3, P4, P6, P7) grew rapidly on all of these media, with the average growth rates ranging from 2.2 to 2.6 mm/d on MEA, from 1.7 to 3.8 mm/d on OA, and from 2.2 to 3.9 mm/d on PDA. After incubation for 14 d, the eight LbR strains and Lb20 formed colonies with yellow, brown, or dark brownish substrate mycelia, whitish fluffy aerial mycelia, and black pycnidia (Figure 2, Figure 3, Figure 4, Figure 5, Figure 6, Figure 7 and Figure 8). Cream or pink pycnidiospore oozes (mucilages) were exuded from the pycnidia and accumulated on the top of the pycnidia. Six LbR strains (P1, P3, P4, P5, P6, P7) and Lb20 produced one-celled pycnidiospores of three different shapes: allantoid (P5, P6, P7), cylindroid (P1, P3, Lb20), and ellipsoid (P4). The remaining two LbR strains (P2, P8) produced both one-celled (majority) and double-celled (minority) pycnidiospores of ellipsoidal shape. Moreover, the eight LbR strains and Lb20 differed greatly in the size of pycnidiospores; six LbR strains (P2, P4, P5, P6, P7, P8) produced large pycnidiospores 8.0 to 8.6 μm in length and 2.7 to 4.4 μm in width, and the remaining two LbR strains (P1, P3) and L. biglobosa Lb20 produced small pycnidiospores 4.2 to 4.9 μm in length and 1.8 to 2.1 μm in width (Table 2). These morphological characteristics matched the species description for Boeremia, Didymella, and Leptosphaeria [13,33], thus validating the above-mentioned phylogenetic identification of the eight LbR strains as five species of Didymella (P1 to P7) and one species of Boeremia (P8).

Table 2.
Mycelial growth rates (20 °C) on three agar media as well as shape and size of the pycnidiospores produced by different fungal strains.

Figure 2.
Morphology of L. biglobosa Lb20. (A,B) Colony on OA (front and reverse); (C,D) colony on MEA (front and reverse); (E,F) colony on PDA (front and reverse). The cultures in (A–F) were incubated at 20 °C for 7 days; (G) colony on PDA (20 °C, 14 d); (H) pycnidia formed on PDA (note the pink pycnidiospore ooze on the surface of the pycnidium); (I) a pycnidium formed on PDA; (J) conidiogenous cells; (K) pycnidiospores (conidia).

Figure 3.
Morphology of Didymella sp. P1. (A,B) Colony on OA (front and reverse); (C,D) colony on MEA (front and reverse); (E,F) colony on PDA (front and reverse). The cultures in (A–F) were incubated at 20 °C for 7 days; (G) colony on PDA (20 °C, 14 d); (H) pycnidia formed on PDA (note the light yellow pycnidiospore ooze on the surface of the pycnidium); (I) a pycnidium formed on PDA; (J,K) sections of pycnidia; (L) conidiogenous cells; (M) pycnidiospores (conidia).

Figure 4.
Morphology of D. macrostoma P2. (A,B) Colony on OA (front and reverse); (C,D) colony on MEA (front and reverse); (E,F) colony on PDA (front and reverse). The cultures in (A–F) were incubated at 20 °C for 7 d; (G) colony on PDA (20 °C, 14 d); (H) pycnidia formed on PDA; (I) a crushed pycnidium formed on PDA; (J,K) sections of two pycnidia; (L) conidiogenous cells; (M) pycnidiospores (conidia).

Figure 5.
Morphology of Didymella sp. P3. (A,B) Colony on OA (front and reverse); (C,D) colony on MEA (front and reverse); (E,F) colony on PDA (front and reverse). The cultures in (A–F) were incubated at 20 °C for 7 days; (G) colony on PDA (20 °C, 14 d); (H) pycnidia formed on PDA (note the purulent pycnidiospore ooze on the surface of the pycnidium); (I) a crushed pycnidium; (J,K) sections of pycnidia; (L) conidiogenous cells; (M) pycnidiospores (conidia).

Figure 6.
Morphology of D. glomerata P4. (A,B) Colony on OA (front and reverse); (C,D) colony on MEA (front and reverse); (E,F) colony on PDA (front and reverse). The cultures in (A–F) were incubated at 20 °C for 7 days; (G) colony on PDA (20 °C, 14 d); (H) pycnidia formed on PDA (note the light purple pycnidiospore ooze on the surface of the pycnidium); (I) a pycnidium formed on PDA; (J,K) sections of pycnidia; (L) pycnidiospores (conidia).

Figure 7.
Morphology of D. macropodii P5. (A,B) Colony on OA (front and reverse); (C,D) colony on MEA (front and reverse); (E,F) colony on PDA (front and reverse). The cultures in (A–F) were incubated at 20 °C for 7 days; (G) colony on PDA (20 °C, 14 d); (H) pycnidia formed on PDA (note the light pycnidiospore ooze on the surface of the pycnidium); (I) a crushed pycnidium; (J,K) sections of pycnidia; (L) conidiogenous cells; (M) pycnidiospores (conidia).

Figure 8.
Morphology of B. exigua P8. (A,B) Colony on OA (front and reverse); (C,D) colony on MEA (front and reverse); (E,F) colony on PDA (front and reverse). The cultures in (A–F) were incubated at 20 °C for 7 days; (G) colony on PDA (20 °C, 14 d); (H) a crushed pycnidium; (I) pycnidiospores (conidia).
3.3. Virulence of the LbRs on Rapeseed
The eight LbR strains differed from L. biglobosa Lb20 in their virulence on cotyledons and the stems of rapeseed (Table 3). L. biglobosa Lb20 caused a severe infection on cotyledons at 7 dpi and on stems at 21 dpi. The average cotyledon lesion diameter reached 8.2 mm; the average lesion length on the stem epidermis and in the stem pith reached 16.3 and 65.3 mm, respectively. In contrast, the eight LbR strains caused a slight infection; they produced small lesions on cotyledons and stems. The average cotyledon lesion diameters ranged from 1.1 to 1.7 mm (13–21% of that for Lb20), the stem epidermal lesion length ranged from 2.0 to 11.7 mm (12–72% of that for Lb20), and the stem pith lesion length ranged from 2 to 30.8 mm (3–47% of that for Lb20).

Table 3.
Pathogenicity of L. biglobosa, Didymella spp., and Boeremia exigua P8 on rapeseed (Brassica napus cultivar Zhongshuang No.9).
3.4. The Effect of the LbRs on Infection by L. biglobosa
The eight LbR strains showed different effects on infection by L. biglobosa Lb20 (Figure 9). Four LbR strains (P1, P2, P3, P4) showed a highly suppressive effect on infection by Lb20; the average lesion diameters in the treatments of P1 + Lb20, P2 Lb20, P3 + Lb20, and P4 + Lb20 at six spore ratios (LbR:Lb20, 2:8, 3:7, 5:5, 7:3, 8:2) were reduced by 30–70%, 63–82%, 58–82%, and 75–83%, respectively, compared to the average lesion diameters caused by Lb20 alone at the corresponding spore concentrations. Three LbR strains (P5, P6, P7) showed a moderately suppressive effect on infection by Lb20; the effect depended on the proportion of their pycnidiospores with Lb20 in the mixed inoculum. In the low-proportion treatments (LbR:Lb20 = 2:8, 3:7, 5:5), the suppressive effect was lower than 15%, whereas in the high-proportion treatments (LbR:Lb20 = 7:3, 8:2), the suppressive effect was increased to 35–48%. The LbR strain P8 had no detectable suppressive effect (<10%) on infection by L. biglobosa.

Figure 9.
Effects of the LbR strains P1 to P8 on infection of cotyledons of rapeseed by L. biglobosa Lb20 (20 °C, 7 d). (A) Cotyledons of different treatments showing difference in lesion size; (B) histograms showing efficacy of the LbR strains in suppression of infection by L. biglobosa. Means ± S.D. labeled with the same letters in each combination of LbR and Lb20 are not significantly different (p > 0.05) according to the least significant difference test.
In the additional experiment, the co-inoculation of D. macrostoma P2 and L. biglobosa Lb20 (1:1) on rapeseed cotyledons also caused a slight infection with the formation of an average lesion diameter of 1.4 mm; the value was significantly (p < 0.01) smaller than that of 8.4 mm caused by L. biglobosa Lb20 alone (Figure 10A,B). Internal colonization of cotyledon tissues by P2 and Lb20 was detected in different zones (Z1, Z2, Z3) around the inoculation point (Figure 10C,D and Figure S3). In the treatment of P2 + Lb20, P2 was isolated in Z1, Z2, and Z3 with isolation frequencies of 64%, 44%, and 32%, respectively; Lb20 was isolated in Z1 and Z2 with lower isolation frequencies (29% and 9%, respectively) than those of P2, but was not isolated in Z3 (Figure 10E). In the treatment of Lb20 alone, Lb20 was isolated at frequencies of 73%, 55%, and 45% in Z1, Z2, and Z3, respectively, whereas P2 was not isolated at all in this treatment due to the absence of P2 in the inoculum (Figure 10F). The above results indicated that P2 can colonize and occupy a certain niche in rapeseed cotyledon, which may be a possible mechanism for limiting L. biglobosa infection.

Figure 10.
Detection of endophytic colonization of rapeseed cotyledons by D. macrostoma P2 and L. biglobosa Lb20. (A) Cotyledons inoculated with pycnidiospore mixture of P2 and Lb20, and pycnidiospores of Lb20 alone; (B) histogram showing lesion diameters in two treatments (data from three trials). ** significantly different at p < 0.01 according to Student’s t test. (C,D) Schematic diagrams for sampling rapeseed cotyledon tissues to strain P2 and Lb20; (E,F) histograms showing isolation frequencies of the two fungi (data from three trials in (E) and only one trial in (F)).
3.5. The Efficacy of Cultural Filtrates of the LbRs in the Suppression of L. biglobosa Infection
The cultural filtrates (CFs) of the eight LbR strains differed in efficacy in the suppression of infection by L. biglobosa Lb20 on rapeseed leaves (Figure 11A). In the control treatment without a CF, a severe infection was observed, and the average lesion diameter reached 12 mm. However, in the treatments with the CF of seven LbR strains (P1, P2, P3, P5, P6, P7, P8), no visible infection or reduced infection was observed. The suppressive efficacy (e.g., reduction in lesion diameter compared to the control treatment) ranged from 30% by P5 CF in P5 CF + Lb20 to 100% by P2 CF in P2 CF + Lb20. In contrast, the P4 CF showed no detectable efficacy in the suppression of L. biglobosa infection; the average lesion diameter reached 13 mm in this treatment (Figure 11A).

Figure 11.
Effects of cultural filtrates of strains P1 to P8 on infection of rapeseed leaves by three rapeseed pathogens. (A) Histogram showing leaf lesion diameters caused by L. biglobosa (Lb) in different treatments (7 dpi, 20 °C). CFs, cultural filtrates; PDB, potato dextrose broth. Means ± S.D. labeled with the same letters are not significantly different (p > 0.05) according to least significant difference test; (B,C) histograms showing leaf lesion diameters caused by S. sclerotiorum (Ss) and B. cinerea (Bc), respectively (20 °C, 3 dpi). ** significantly different at p < 0.01 according to Student’s t test.
Moreover, P2 CF showed high efficacy in the suppression of infection by B. cinerea and S. sclerotiorum on rapeseed leaves. In the control treatments, both B. cinerea and S. sclerotiorum aggressively colonized rapeseed leaves, causing necrotic lesions at 3 dpi with average lesion diameters of 8 and 15 mm by B. cinerea and S. sclerotiorum, respectively (Figure 11B,C). However, no visible infection was observed in the treatments with P2 CF, and a slight infection was observed when inoculated with Ss-1 with the formation of tiny lesions 1 mm in diameter. The results also showed that the color of the rapeseed leaves treated with P2 CF and water alone appeared green (Figure S4), suggesting that P2 CF may have no phytotoxicity towards rapeseed leaves.
3.6. The Antifungal Activity of P2 CF and P2 PS
In the agar diffusion assay, P2 CF in Oxford cups diffused into PDA containing pycnidiospores of L. biglobosa Lb20 and caused the formation of inhibition zones (e.g., clear zones) around the Oxford cups due to the inhibition of germination of pycnidiospores and the elongation of term tubes (Figure 12A), whereas fresh PDB in the Oxford cups failed to form inhibition zones due to normal pycnidiospore germination and germ tube elongation (Figure 12B). The results also showed that P2 PS (e.g., pycnidiospore-associated substances, Figure 12C) in the Oxford cups caused the formation of inhibition zones on PDA also containing pycnidiospores of L biglobosa Lb20 (Figure 12D), indicating antifungal activity towards L. biglobosa. However, P2 PS failed to produce inhibition zones on the P2 pycnidiospores added PDA (Figure 12E), indicating no antifungal activity towards P2 itself.
Figure 12.
Specific antifungal activity of D. macrostoma P2 to L. biglobosa in the agar diffusion assay (20 °C, 4 d). (A) Two clear zones around two Oxford cups containing P2 CFs; note inhibition of L. biglobosa spore germination and germ tube elongation. (B) No clear zone formation around two Oxford cups containing fresh PDB; note normal pycnidiospore germination of L. biglobosa and germ tube elongation. (C) PDA culture of P2 with sticky pycnidiospore mucilages exuded from pycnidia; the mucilages were washed off with water for preparation of a pycnidiospore suspension, and pycnidiospore-associated substances (e.g., P2 PSs) were dissolved in the pycnidiospore suspension. (D) Two clear zones caused by P2 PSs and no clear zones caused by water on PDA containing pycnidiospores of L. biglobosa; (E) no clear zones caused by P2 PSs and water on PDA containing pycnidiospores of D. macrostoma P2.
In the agar amendment bioassay, the P2 CF added in PDA at 0.1% to 5.0% (v/v) significantly (p < 0.05) reduced the colony size of L. biglobosa, S. sclerotiorum, and B. cinerea, compared to the colony size of these fungi on PDA without P2 CF alone (Figure 13A). With the increase in the concentration of P2 CFs from 0.1% to 5.0%, the inhibition rates (e.g., the percentage of colony size reduction) were consistently increased from 49% to 92% for L. biglobosa, from 33% to 89% for S. sclerotiorum, and from 20% to 70% for B. cinerea (Figure 13B).
Figure 13.
Inhibition of fungal mycelial growth by cultural filtrates (CFs) of D. macrostoma P2 in an agar amendment assay. (A) Fungal colonies on PDA alone and in PDA with P2 CFs added at different concentrations. (B) Inhibition rates against the three pathogens. Means ± S.D. in each figure labeled with the same letter are not significantly different (p > 0.05) according to least significant difference test.
3.7. Penicillither Yield and Antifungal Activity
The purified fraction Fr.4.4 was a light-yellow amorphous powder (Figure S1), and it was soluble in methanol and DMSO. LC-MS detection showed that the peak intensity ratio at m/z 395 [M-H]− and 397 [M-H+2]− was approximately 3:1, and this ratio was also observed at m/z 419 [M+Na]+ and 421 [M+Na+2]+. These results indicate that there is a chlorine atom in Fr.4.4 (Figure 14A) [34]. The molecular formula of Fr.4.4 was thus deduced to be C18H17O8Cl based on the positive HR ESI-MS spectrum (m/z: observed 419.0503 [M+Na]+, calculated 419.0510) and the negative HR ESI-MS spectrum (m/z: observed 395.0517 [M-H]−, calculated 395.0534). CAS SciFinder® (https://origin-scifinder.cas.org (accessed on 28 November 2023)) indicates that Fr.4.4 might belong to penicillither or methyl 3-chloroasterric acid. UV absorption determination indicated that Fr.4.4 formed three characteristic absorption peaks at 222, 264, and 318 nm (Figure 14B), suggesting that this compound is penicillither, and this was confirmed by the partial data of the 1H-NMR (DSMO, 600 MHz) and 13C NMR (DSMO, 125 MHz) spectra (Table 4; Figures S5 and S6). Quantitative analysis indicated that the content of penicillither was 45.5% in P2 CE, and the concentration of penicillither was 127.3 ± 18.6 μg/mL in P2 CF and 117.8 ± 21.5 μg/mL in P2 PS (1 × 108 spores/mL). The agar diffusion bioassay showed that penicillither had antifungal activity towards L. biglobosa (Figure 14C), and it produced inhibition diameters of 1.8 and 2.3 cm at concentrations of 50 and 100 μg/mL, respectively.

Figure 14.
Identification of penicillither produced by D. macrostoma P2. (A) LC-MS spectra in negative and positive modes for calculation of molecular mass and inference of molecular formula; (B) UV-Vis spectrum; (C) chemical structure; and (D) antifungal activity against L. biglobosa.

Table 4.
Partial 1H and 13C NMR spectra of penicillither produced by D. macrostoma P2.
4. Discussion
The present study clarified the taxonomic status of the eight LbR strains (P1 to P8). They belong to the same family, namely, Didymellaceae. Seven LbR strains belong to five species of Didymella, including two unidentified species of Didymella (P1, P3), D. macrostoma (P2), D. glomerata (P4), and D. macropodii (P5, P6, P7). The remaining one, namely strain P8, belongs to Boeremia exigua. All of these didymellaceous species had the telemorphs of Phoma [33]. Molecular phylogeny suggests that the LbR strains are distantly related to L. biglobosa (anamorph: Plenodomus biglobosus), which belongs to the family Leptosphaeriaceae. Strains P1 and P3 are closely related to D. bellidis; they formed two unique branches, suggesting that they might belong to two novel species. A definition of these two taxa as novel species of Didymella will be finalized in the future when more strains are collected.
D. macrostoma, D. glomerata, D. macropodii, and B. exigua can be plant pathogens [13]. For example, D. macrostoma can cause leaf spot on Pinckneya pubens [36], leaf chlorosis and necrosis on Cirsium arvense [37], and root and crown disease on Lepidium draba [38]. D. glomerata can cause leaf blight and twig canker on Pyrus communis [39], as well as leaf blight on Pistacia vera [40]; D. macropodii can cause hypocotyl discoloration and constriction on Brassica napus [41]; and B. exigua var. exigua can cause black (tan) spot on Glycine max [42], Phaseolus lunatus [43], and Pisum sativum [44], as well as post-harvest fruit rot on Malus × domestica [45]. Recently, B. exigua var. exigua was reported to occur in China, causing branch blight on Juglans sinensis [46]. However, the eight LbR strains obtained in this study are probably not the pathogens or at least not the important pathogens of oilseed rape. First, the LbR strains occurred at the frequency of 0.1% (8 strains in 6023 strains; Deng et al., 2023); the value was much lower than that of 99.9% for L. biglobosa in the same ecological niches as the LbR strains. Second, the LbR strains showed significantly (p < 0.05) lower virulence than L. biglobosa. Therefore, they are probably occasional intruders on stems readily colonized by L. biglobosa. Moreover, previous studies indicated that D. macrostoma and D. glomerata can be endophytes living in plant tissues without causing visible disease symptoms [47,48]. In this study, D. macrostoma P2 and D. glomerata P4 caused negligible infection both in cotyledons and in the stems of oilseed rape. This study found that D. macrostoma P2 was consistently isolated from healthy cotyledon tissues distant from the inoculation points of D. macrostoma P2 and L. biglobosa Lb20. This result suggests that D. macrostoma P2 is an endophyte of rapeseed. Further studies using visible markers (e.g., green fluorescent protein) to probe the endophytic colonization of D. macrostoma P2 in tissues of rapeseed are warranted.
Meanwhile, the taxonomic position of 15 strains of L. biglobosa was also clarified based on molecular phylogenies with the DNA sequences of ITS, LSU, tub2, and rpb2, and they all belong to L. biglobosa (anamorph: Plenodomus) [49]. Phylogenetic analysis with the DNA sequences of ITS and LSU also showed that the 15 strains of L. biglobosa are more closely related to L. biglobosa ‘brassicae’. This subspecies is distributed widely in the south of China, where the winter-type oilseed rape is widely planted [50,51]. Recently, Luo et al. (2021) and Deng et al. (2023) reported that L. biglobosa ‘canadensis’ is the dominant and widespread blackleg pathogen of rapeseed in the north of China [23,52], where the spring-type rapeseed is widely planted. The reasons for the differential distribution of L. biglobosa ‘brassicae’ and L. biglobosa ‘canadensis’ in China remain unknown and need further investigation.
The present study demonstrated that D. macrostoma P2 significantly suppressed infection by L. biglobosa on rapeseed cotyledons when it was co-inoculated with L. biglobosa. Two mechanisms might be involved in the suppression of L. biglobosa infection by D. macrostoma P2. One is the production of antifungal metabolites in the pycnidiospores of D. macrostoma P2, and the other is the endophytic colonization of rapeseed plant tissues by D. macrostoma P2. We found that the P2 PSs (pycnidiospore-associated substances) had inhibitory activity on L. biglobosa. The inhibition might occur in the inoculation points with D. macrostoma P2 and L. biglobosa Lb20. Previous studies showed that L. biglobosa can conduct endophytic growth in rapeseed tissues during the period of latent infection [53,54]. However, D. macrostoma displayed more aggressiveness than L. biglobosa in the endophytic colonization of cotyledons of rapeseed, thereby generating suppression against infection by L. biglobosa. Previous studies have demonstrated that endophytic fungi could play a beneficial role in plants under certain circumstances [55,56,57]. For example, non-pathogenic endophytic strains of Fusarium oxysporum could yield a biocontrol effect on infection by pathogenic F. oxysporum [58]. Additional studies are necessary to investigate the mechanisms of enphytic growth of D. macrostoma P2 and to evaluate the biocontrol effects of the enphytic growth of D. macrostoma P2 on rapeseed diseases, including clubroot (Plasmodiophora brassicae), sclerotinia stem rot (S. sclerotiorum), and blackleg (L. biglobosa).
In addition to inhibiting L. biglobosa, the cultural filtrates (CFs) of D. macrostoma P2 showed high efficacy in the suppression of B. cinerea and S. sclerotiorum on rapeseed leaves. These results suggest that D. macrostoma P2 and the antifungal metabolites produced by this fungus have a wide inhibitory spectrum. Previous studies by Aire et al. [17,18] showed that D. glomerata (a close relative of D. macrostoma) is an effective biocontrol agent against rapeseed clubroot through the production of epoxydon. D. macrostoma has been tested to control broadleaf weeds such as Canadian thistle (Cirsium arvense) [19,59], and strain 94–44B of D. macrostoma has been registered as a bioherbicide in Canada and the USA [37]. This study showed that the metabolites of D. macrostoma P2 had no detectable phytotoxicity towards leaves of rapeseed. Therefore, the antifungal metabolites of D. macrostoma P2 can be exploited to control B. cinerea and S. sclerotiorum. Additional studies are necessary to determine the efficacy of the antifungal metabolites produced by these particular strains of D. macrostoma in the suppression of rapeseed diseases under field conditions.
Previous studies have reported several bioactive metabolites produced by D. macrostoma, including macrocidins (e.g., cyclic tetramic acids) with herbicidal activity [19,59], oxazole carboxylic acids with antibacterial and anti-tumor activities [60], as well as mono-(2-ethylhexyl) phthalate with antibacterial and antifungal activities [47]. In this study, we found that the application of P2 CFs on rapeseed leaves effectively suppressed infection by L. biglobosa, B. cinerea, and S. sclerotiorum. However, it did not cause any visible phytotoxicity towards rapeseed leaves, suggesting that D. macrostoma P2 may have no capability to synthesize macrocidins. Meanwhile, we identified an antifungal metabolite, namely penicillither, in PDB cultures and pycnidiospore suspensions of D. macrostoma P2. Penicillither was first isolated and identified in Penicillium PSU-RSPG99 [61] and in later studies on Aspergillus capensis and A. flaviceps [35,62]. Penicillither has a diphenyl ether skeleton structure, and its benzene ring contains a chlorine atom, which is a chlorinated diphenyl ether compound. It is also a homologue of asterric acid, which is diverse in structure and biological activity. In 1960, asterric acid was first isolated from the fermentation broth of Aspergillus terreus [63]. In addition, Jayasuriya et al. (1995) identified a variety of asterric acid analogues from the fermentation broth of Phoma sp., two of which had inhibitory activity against the new tetrapeptide chalchol-invertase (FPTase) [64]. In future studies, it is necessary to sequence the whole genome of D. macrostoma P2, which can be used to mine the genes for the biosynthesis of the secondary metabolites in that fungus.
5. Conclusions
This research demonstrated that Didymella macrostoma P2 is a broad-spectrum antimicrobial agent that can be exploited to control rapeseed diseases caused by L. biglobosa, B. cinerea, and S. sclerotiorum. D. macrostoma P2 is a novel producer of penicillither, which was detected both in PDB cultures and in pycnidiospore mucilages. Moreover, this study found that D. macrostoma P2 could possibly restrict L. biglobosa infection in rapeseed cotyledons through the production of penicillither and the aggressive endophytic occupation of the ecological niche. At present, the endophytic mechanism of D. macrostoma P2 remains totally unknown and needs further investigation, as this can improve the applicability of using D. macrostoma P2 to control rapeseed disease. Overall, this study provides a case study of screening pathogen-associated fungi as biocontrol agents.
Supplementary Materials
The following supporting information can be downloaded at: https://www.mdpi.com/article/10.3390/jof9121167/s1, Figure S1: The procedure for purification of the fraction of Fr. 4.4 and determination of purity of the sub-fraction Fr.4.4.; Figure S2: A Bayesian phylogenetic tree of 38 fungal taxa.The tree was constructed using concatenated sequences of ITS and LSU; Figure S3: Isolation of D. macrostoma P2 and L. biglobosa Lb20 in rapeseed cotyledons; Figure S4: Two leaves of rapeseed treated with the culture filtrate (CF) of D. macrostoma P2 and PDB alone; Figure S5: 13C NMR (125 MHz, DSMOMeOH-d6, NMR) spectrum for penicillither from Didymella macrostoma P2; Figure S6: 1H NMR (600 MHz, DSMO-d6, NMR) spectrum for penicillither A from Didymella macrostoma P2; Table S1: PCR primers used in this study for amplification of different genes; Table S2: PCR thermal programs for amplification of different fungal genes; Table S3: Origin of the fungal isolates used in this study and GenBank accession numbers; Refs [65,66,67,68,69] are cited in Supplementary Materials.
Author Contributions
J.Z., G.L. and J.C. designed the study; J.C. performed the experiments; T.L. analyzed the data; L.Y., J.Z. and M.W. collected the rapeseed samples; J.C., J.Z., W.C. and G.L. wrote the paper. All authors have read and agreed to the published version of the manuscript.
Funding
We appreciate the financial support from the earmarked fund of the China Agriculture Research System (CARS) of the Ministry of Agriculture and Rural Affairs of the People’s Republic of China (CARS-12-22).
Institutional Review Board Statement
Not applicable.
Informed Consent Statement
Not applicable.
Data Availability Statement
Data is contained within the article and Supplementary Material.
Conflicts of Interest
The authors declare no conflict of interest.
References
- Wang, H.Z. New demand-oriented rapeseed industry developing strategy. Chin. J. Oil Crop Sci. 2018, 40, 613–617. [Google Scholar]
- Zheng, X.; Koopmann, B.; Ulber, B.; von Tiedemann, A. A global survey on diseases and pests in oilseed rape-current challenges and innovative strategies of control. Front. Agron. 2020, 2, 590908. [Google Scholar] [CrossRef]
- Liban, S.H.; Cross, D.J.; Kutcher, H.R.; Peng, G.; Fernando, W.G.D. Race structure and frequency of avirulence genes in the western Canadian Leptosphaeria maculans pathogen population, the causal agent of blackleg in brassica species. Plant Pathol. 2016, 65, 1161–1169. [Google Scholar] [CrossRef]
- Fitt, B.D.L.; Brun, H.; Barbetti, M.J.; Rimmer, S.R. World-wide importance of phoma stem canker (Leptosphaeria maculans and L. biglobosa) on oilseed rape (Brassica napus). Eur. J. Plant Pathol. 2006, 114, 3–15. [Google Scholar] [CrossRef]
- Fitt, B.D.L.; Huang, Y.J.; Bosch, F.V.D.; West, J.S. Coexistence of related pathogen species on arable crops in space and time. Annu. Rev. Phytopathol. 2006, 44, 163–182. [Google Scholar] [CrossRef]
- Bolton, M.D.; Thomma, B.P.H.J.; Nelson, B.D. Sclerotinia sclerotiorum (Lib.) de Bary: Biology and molecular traits of a cosmopolitan pathogen. Mol. Plant Pathol. 2006, 7, 1–16. [Google Scholar] [CrossRef]
- Williamson, B.; Tudzynsk, B.; Tudzynski, P.; van Kan, J.A.L. Botrytis cinerea: The cause of grey mould disease. Mol. Plant Pathol. 2007, 8, 561–580. [Google Scholar] [CrossRef]
- McLaren, D.L.; Huang, H.C.; Rimmer, S.R. Control of apothecial production of Sclerotinia sclerotiorum by Coniothyrium minitans and Talaromyces flavus. Plant Dis. 1996, 80, 1373–1378. [Google Scholar] [CrossRef]
- Fravel, D.R. Commercialization and implementation of biocontrol. Annu. Rev. Phytopathol. 2005, 43, 337–359. [Google Scholar] [CrossRef]
- Tewari, J.P.; Shinners, T.C.; Briggs, K.G. Production of calcium oxalate crystals by two species of Cyathus in culture and in infested plant debris. Verl. Z. Für Naturforschung 1997, 52, 421–425. [Google Scholar] [CrossRef]
- Danielsson, J.; Reva, O.; Meijer, J. Protection of rapeseed (Brassica napus) toward fungal pathogens by strains of plant-associated Bacillus amyloliquefaciens. Microbial Ecol. 2007, 54, 134–140. [Google Scholar] [CrossRef] [PubMed]
- Abuamsha, R.; Salman, M.; Ehlers, R.U. Effect of seed priming with Serratia plymuthica and Pseudomonas chlororaphis to control Leptosphaeria maculans in different rapeseed cultivars. Eur. J. Plant Pathol. 2011, 130, 287–295. [Google Scholar] [CrossRef]
- Boerema, G.H.; de Gruyter, J.; Noordeloos, M.E.; Hamers, M.E.C. Phoma Identifcation Manual; CABI Publishing: Wallingford, UK, 2004. [Google Scholar]
- Aveskamp, M.M.; de Gruyter, J.; Crous, P.W. Biology and recent developments in the systematics of Phoma, a complex genus of major quarantine signifcance. Fungal Divers. 2008, 31, 1–18. [Google Scholar]
- Aveskamp, M.M.; de Gruyter, J.; Woudenberg, J.H.C.; Verkley, G.J.M.; Crous, P.W. Highlights of the Didymellaceae: A polyphasic approach to characterise Phoma and related pleosporalean genera. Stud. Mycol. 2010, 65, 1–60. [Google Scholar] [CrossRef] [PubMed]
- Wang, L.W.; Xu, B.G.; Wang, J.Y.; Su, Z.Z.; Lin, F.C.; Zhang, C.L.; Kubicek, C.P. Bioactive metabolites from Phoma species, an endophytic fungus from the Chinese medicinal plant Arisaema erubescens. Appl. Microbiol. Biotechnol. 2011, 93, 1231–1239. [Google Scholar] [CrossRef] [PubMed]
- Arie, T.; Hobayashi, Y.; Okada, G.; Kono, Y.; Yamaguchi, I. Control of soilborne clubroot disease of cruciferous plants by epoxydon from Phoma glomerata. Plant Pathol. 1998, 47, 743–748. [Google Scholar] [CrossRef]
- Arie, T.; Kobayashi, Y.; Kono, Y.; Okada, G.; Yamaguchi, I. Control of clubroot of crucifers by Phoma glomerata and its product. Pest Sci. 1999, 55, 566–614. [Google Scholar] [CrossRef]
- Graupner, P.R.; Carr, A.; Clancy, E.; Gilbert, J.; Bailey, K.L.; Derby, J.-A.; Gerwick, B.C. The macrocidins: Novel cyclic tetramic acids with herbicidal activity produced by Phoma macrostoma. J. Nat. Prod. 2003, 66, 1558–1561. [Google Scholar] [CrossRef]
- Sullivan, R.F.; White, J.F.J.R. Phoma glomerata as a mycoparasite of powdery mildew. Appl. Environ. Microb. 2000, 66, 425–427. [Google Scholar] [CrossRef]
- Strobel, G.; Daisy, B.; Castillo, U.; Harper, J. Natural products from endophytic microorganisms. J. Nat. Prod. 2004, 67, 257–268. [Google Scholar] [CrossRef]
- Strobel, G.; Singh, S.K.; Riyaz-UI-Hassan, S.; Mitchell, A.M.; Geary, B.; Sears, J. An endophytic/pathogenic Phoma sp. from creosote bush producing biologically active volatile compounds having fuel potential. FEMS Microbiol. Lett. 2011, 320, 87–94. [Google Scholar] [CrossRef] [PubMed]
- Deng, Y.; Li, J.C.; Lyv, X.; Xu, J.W.; Wu, M.D.; Zhang, J.; Yang, L.; Li, G.Q. Large-scale surveys of blackleg of rapeseed (Leptosphaeria biglobosa) revealed new insights into epidemics of this disease in China. Plant Dis. 2023, 107, 1408–1417. [Google Scholar] [CrossRef] [PubMed]
- Fu, M.; Crous, P.W.; Bai, Q.; Zhang, P.F.; Xiang, J.; Guo, Y.S.; Zhao, F.F.; Yang, M.M.; Hong, N.; Xu, W.X.; et al. Colletotrichum species associated with anthracnose of Pyrus spp. in China. Persoonia 2019, 42, 1–35. [Google Scholar] [CrossRef] [PubMed]
- Kumar, S.; Stecher, G.; Tamura, K. MEGA7: Molecular evolutionary genetics analysis version 7.0 for bigger datasets. Mol. Evol. Genet. Anal. 2016, 33, 1870–1874. [Google Scholar] [CrossRef]
- Guo, Y.S.; Crous, P.W.; Bai, Q.; Fu, M.; Yang, M.M.; Wang, X.H.; Du, Y.M.; Hong, N.; Xu, W.X.; Wang, G.P.; et al. High diversity of Diaporthe species associated with pear shoot canker in China. Persoonia 2020, 45, 132–162. [Google Scholar] [CrossRef]
- Ronquist, F.; Huelsenbeck, J.P. MrBayes 3: Bayesian phylogenetic inference under mixed models. Bioinformatics 2003, 19, 1572–1574. [Google Scholar] [CrossRef]
- Nylander, J.A.A. MrModelTest v. 2. Program Distributed by the Author; Evolutionary Biology Centre, Uppsala University: Uppsala, Sweden, 2004. [Google Scholar]
- Swofford, D. PAUP 4.0 b10: Phylogenetic analysis using parsimony (*and other methods). In Computer Programme; Sinauer Associates: Sunderland, MA, USA, 2002. [Google Scholar]
- Edler, D.; Klein, J.; Antonelli, A.; Silvestro, D. raxmlGUI 2.0: A graphical interface and toolkit for phylogenetic analyses using RAxML. Methods Ecol. Evol. 2020, 12, 373–377. [Google Scholar] [CrossRef]
- Hillis, D.M.; Bull, J.J. An empirical test of bootstrapping as a method for assessing confidence in phylogenetic analysis. Syst. Biol. 1993, 42, 182–192. [Google Scholar] [CrossRef]
- Rambaut, A. FigTree, v. 1.4.2. Institute of Evolutionary Biology. University of Edinburgh. Available online: http://tree.bio.ed.ac.uk/software/figtree/ (accessed on 1 June 2020).
- Chen, Q.; Jiang, J.R.; Zhang, G.Z.; Cai, L.; Crous, P.W. Resolving the Phoma enigma. Stud. Mycol. 2015, 82, 137–217. [Google Scholar] [CrossRef]
- Lee, H.J.; Lee, J.H.; Hwang, B.P.; Kim, H.S.; Lee, J.J. Fungal metabolites, asterric acid derivatives inhibit vascular endothelial growth factor (VEGF)-induced tube formation of HUVECs. J. Antibiot. 2002, 55, 552–556. [Google Scholar] [CrossRef]
- Chen, W.J. Studies on Antibacterial Ingredients from the Marine Fungus Aspergillus flavipes. Master’s Thesis, Harbin University of Commerce, Harbin, China, 2020. [Google Scholar]
- Baird, R.E. First report of Phoma macrostoma causing leaf spot on fevertree. Plant Dis. 1993, 77, 1168. [Google Scholar] [CrossRef]
- Evans, H.C.; Seier, M.K.; Derby, J.-A.; Falk, S.; Bailey, K.L. Tracing the origins of white tip disease of Cirsium arvense and its causal agent, Phoma macrostoma. Weed Res. 2013, 53, 42–52. [Google Scholar] [CrossRef]
- Caesar, A.J.; Lartey, R.T.; Caesar-Ton-That, T.C. First report of a root and crown disease of the invasive weed Lepidium draba caused by Phoma macrostoma. Plant Dis. 2012, 96, 145. [Google Scholar] [CrossRef] [PubMed]
- Chohan, J.S.; Chand, T. Phoma glomerata, a new pathogen om pears (Pyrus communis). Trans. Br. Mycol. Society 1980, 75, 509. [Google Scholar] [CrossRef]
- Moral, J.; Lichtemberg, P.S.F.; Papagelis, A.; Sherman, J.; Michailides, T.J. Didymella glomerata causing leaf blight on pistachio. Eur. J. Plant Pathol. 2018, 151, 1095–1099. [Google Scholar] [CrossRef]
- Boerema, G.H.; Loerakker, W.M.; Wittern, I. Zum Auftreten von Phoma nigrificans (P. Karst.) comb. nov. (teleomorph Didymella macropodii Petrak) an Winterraps (Brassica napus L. var. oleifera Metzger). J. Phytopathol. 1986, 115, 167–273. [Google Scholar] [CrossRef]
- Schaffrath, U.; Vogel, L.; Loehrer, M. First report of Boeremia exigua var. exigua causing black spot-like symptoms on commercially grown soybean in Germany. Plant Dis. 2021, 105, 219. [Google Scholar] [CrossRef]
- Pethybridge, S.J.; Hay, F.S.; Gorny, A. Spatiotemperal attributes and crop loss associated with tan spot epidemics in baby lima bean in New York. Plant Dis. 2018, 102, 405–412. [Google Scholar] [CrossRef]
- Li, Y.P.; You, M.P.; Finnegan, P.M.; Khan, T.N.; Lanoiselet, V.; Eyres, N.; Barbetti, M.J. First report of black spot caused by Boeremia exigua var. exigua on field pea in Australia. Plant Dis. 2012, 96, 148. [Google Scholar]
- Thomidis, T.; Zambounis, A.; Prodromou, I. Occurrence of a postharvest fruit rot disease of apples caused by Boeremia exigua var. exigua in Ptolemaida Kozani, Greece. Plant Dis. 2016, 100, 2333. [Google Scholar]
- Cai, F.F.; Yang, C.D.; Ma, T.; Jin, M.J.; Cui, L.X. First report of Boeremia exigua var. exigua causing branch blight on walnut in China. Plant Dis. 2021, 105, 3291. [Google Scholar] [CrossRef] [PubMed]
- Yang, X.; Ma, Y.P.; Wang, J.W.; Wei, X.Y. Antibacterial substances of endophytic fungus isolated from Pueraria lbata. J. Shaanxi Norm. Univ. 2014, 42, 71–74. [Google Scholar]
- Waqas, M.; Khan, A.L.; Kamran, M.; Hamayun, M.; Kang, S.-M.; Kim, Y.-H.; Lee, I.-J. Endophytic fungi produce gibberellins and indoleacetic acidand promotes host-plant growth during stress. Molecules 2012, 17, 10754–10773. [Google Scholar] [CrossRef] [PubMed]
- de Gruyter, J.; Woudenberg, J.H.C.; Aveskamp, M.M.; Verkley, G.J.M.; Groenewald, J.Z.; Crous, P.W. Redisposition of Phoma-like anamorphs in Pleosporales. Stud. Mycol. 2012, 75, 1–36. [Google Scholar] [CrossRef] [PubMed]
- Liu, Z.; Latunde-Dada, A.O.; Hall, A.M.; Fitt, B.D.L. Phoma stem canker disease on oilseed rape (Brassica napus) in China is caused by Leptosphaeria biglobosa ‘brassicae’. Eur. J. Plant Pathol. 2014, 140, 841–857. [Google Scholar] [CrossRef]
- Cai, X.; Huang, Y.J.; Jiang, D.H.; Fitt, B.D.L.; Li, G.Q.; Yang, L. Evaluation of oilseed rape seed yield losses caused by Leptosphaeria biglobosa in central China. Eur. J. Plant Pathol. 2018, 150, 179–190. [Google Scholar] [CrossRef]
- Luo, T.; Li, G.Q.; Yang, L. First report of Leptosphaeria biglobosa ‘canadensis’ causing blackleg on oilseed rape (Brassica napus) in China. Plant Dis. 2021, 105, 3760. [Google Scholar] [CrossRef]
- Nathaniels, N.Q.R.; and Taylor, G.S. Latent infection of winter oilseed rape by Leptosphaeria maculans. Plant Pathol. 1983, 32, 23–31. [Google Scholar] [CrossRef]
- Zhang, Q.H.; Zhang, J.; Yang, L.; Zhang, L.; Jiang, D.H.; Chen, W.D.; Li, G.Q. Diversity and biocontrol potential of endophytic fungi in Brassica napus. Biol. Control 2014, 72, 98–108. [Google Scholar] [CrossRef]
- Arnold, A.E.; Mejia, L.C.; Kyllo, D.; Rojas, E.I.; Maynard, Z.; Robbins, N.; Herre, E.A. Fungal endophytes limit pathogen damage in a tropical tree. Proc. Natl. Acad. Sci. USA 2003, 100, 15649–15654. [Google Scholar] [CrossRef]
- Rodriguez, R.J.; White, J.F.; Arnold, A.E.; Redman, R.S. Fungal endophytes: Diversity and functional roles. New Phytol. 2009, 182, 314–330. [Google Scholar] [CrossRef] [PubMed]
- Bonfante, P.; Genre, A. Mechanisms underlying beneficial plant fungus interactions in mycorrhizal symbiosis. Nat. Commun. 2010, 1, 48. [Google Scholar] [CrossRef] [PubMed]
- De Lamo, F.J.; Takken, F.L.W. Biocontrol by Fusarium oxysporum using endophyte mediated resistance. Front. Plant Sci. 2020, 11, 37. [Google Scholar] [CrossRef] [PubMed]
- Pitt, W.M.; Bailey, K.L.; Fu, Y.B.; Peterson, G.W. Biological and genetic characterisation of Phoma macrostoma isolates with bioherbicidal activity. Biocontrol Sci. Technol. 2012, 22, 813–835. [Google Scholar] [CrossRef]
- Kemkuignou, B.M.; Treiber, L.; Zeng, H.X.; Schrey, H.; Schobert, R.; Stadler, M. Macrooxazoles A-D, new 2,5-disubstituted oxazole-4-carboxylic acid derivatives from the plant pathogenic fungus Phoma macrostoma. Molecules 2020, 25, 5497. [Google Scholar] [CrossRef] [PubMed]
- Rukachaisirikul, V.; Satpradit, S.; Klaiklay, S.; Phongapaichit, S.; Borwornwiriyapan, K.; Sakayaroj, J. Polyketide anthraquinone, diphenyl ether, and xanthone derivatives from the soil fungus Penicillium sp. PSU-RSPG99. Tetrahedron 2014, 70, 5148–5152. [Google Scholar] [CrossRef]
- Qin, J.; Lyu, A.; Zhang, Q.H.; Yang, L.; Zhang, J.; Wu, M.D.; Li, G.Q. Strain identification and metabolites isolation of Aspergillus capensis CanS-34A from Brassica napus. Mol. Biol. Rep. 2019, 46, 3451–3460. [Google Scholar] [CrossRef]
- Curtis, R.F.; Hassalld, C.H.; Jones, D.W.; Williams, T.W. The biosynthesis of phenols. Part II. Asterric acid, a metabolic product of Aspergillus terreus Thorn. J. Chem. Soc. 1960, 940, 4838–4842. [Google Scholar] [CrossRef]
- Jayasuriya, H.; Ball, R.G.; Zink, D.L.; Smith, J.L.; Goetz, M.A.; Jenkins, R.G.; Nallin-Omstead, M.; Silverman, K.C.; Bills, G.F.; Lingham, R.B.; et al. Barceloneic acid A, a new farnesyl-protein transferase inhibitor from a Phoma species. J. Nat. Prod. 1995, 58, 986–991. [Google Scholar] [CrossRef]
- de Hoog, G.S.; Gerrits van den Ende, A.H. Molecular diagnostics of clinical strains of filamentous Basidiomycetes. Mycoses 1998, 41, 183–189. [Google Scholar] [CrossRef]
- Liu, Y.J.; Whelen, S.; Hall, B.D. Phylogenetic relationships among ascomycetes: Evidence from an RNA polymerse II subunit. Mol. Biol. Evol. 1999, 16, 1799–1808. [Google Scholar] [CrossRef] [PubMed]
- Vilgalys, R.; Hester, M. Rapid genetic identification and mapping of enzymatically amplified ribosomal DNA from several Cryptococcus species. J. Bacteriol. 1990, 172, 4238–4246. [Google Scholar] [CrossRef] [PubMed]
- Woudenberg, J.H.; Aveskamp, M.M.; de Gruyter, J.; Spiers, A.G.; Crous, P.W. Multiple Didymella teleomorphs are linked to the Phoma clematidina morphotype. Persoonia 2009, 22, 56–62. [Google Scholar] [CrossRef]
- White, T.J. Amplification and Direct Sequencing of Fungal Ribosomal RNA Genes for Phylogenetics. In PCR Protocols, a Guide to Methods and Applications; Wiley: Hoboken, NJ, USA, 1990; pp. 315–322. [Google Scholar]
Disclaimer/Publisher’s Note: The statements, opinions and data contained in all publications are solely those of the individual author(s) and contributor(s) and not of MDPI and/or the editor(s). MDPI and/or the editor(s) disclaim responsibility for any injury to people or property resulting from any ideas, methods, instructions or products referred to in the content. |
© 2023 by the authors. Licensee MDPI, Basel, Switzerland. This article is an open access article distributed under the terms and conditions of the Creative Commons Attribution (CC BY) license (https://creativecommons.org/licenses/by/4.0/).